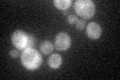
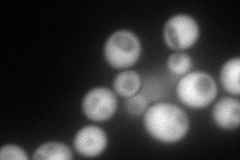
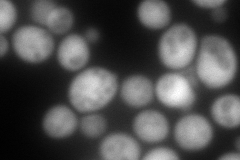
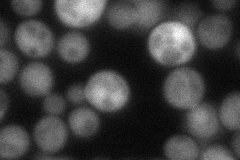
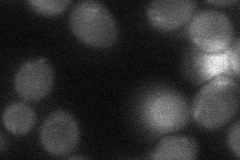
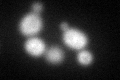
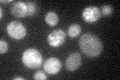

View description
Asn rich cytoplasmic protein that contains RGG motifs; high-copy suppressor of group II intron-splicing defects of a mutation in MRS2 and of a conditional mutation in POL1 (DNA polymerase alpha); possible role in mitochondrial mRNA splicing
Localization:
Intensity:
Fold change:
Significance:
-
C’ GFP library in SD
cytosol39.9 -
N' NOP1pr-GFP in SD
cytosol238.439 -
N' TEF2pr-mCherry in SD
cytosol334.704 -
N' NATIVEpr-GFP in SD
cytosol59.5203 -
N' TEF2pr-VC and Cyto-VN in SD
cytosol34.6696 -
C’ GFP library in SD+DTT
cytosol50.551.26No -
C’ GFP library in SD+H2O2

cytosol36.80.92No -
C’ GFP library in Starvation Media
cytosol41.071.02No -
C’ GFP library on the background of Pup2-DaMP

cytosol -
C’ GFP library on the background of CCT mutant

cytosol55.81631.39842Yes
